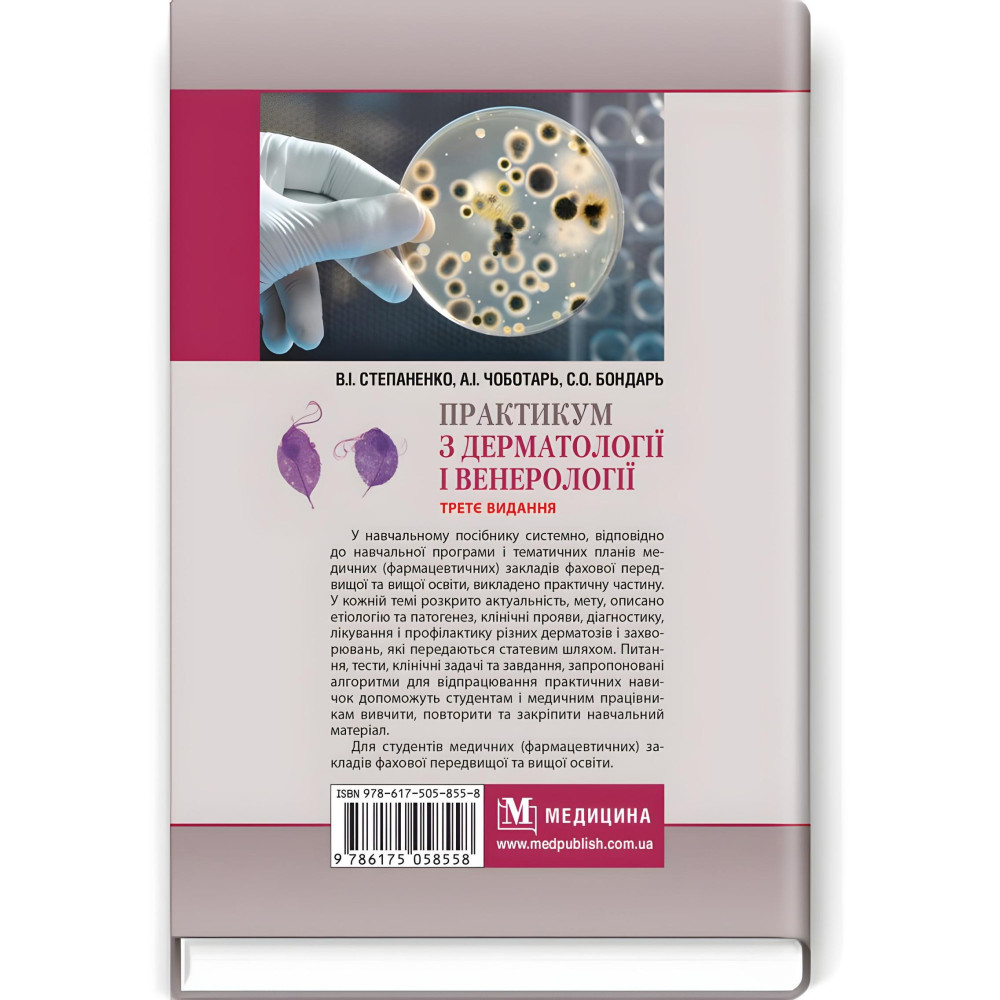

Практикум по дерматологии и венерологии: учебное пособие/В.И. Степаненко, А.И. Чеботарь, С.А. Бондарь и другие. — 3-е издание
| Издательство: | Всеукраїнське спеціалізоване видавництво «Медицина» |
| Артикул: | PB-011850 |
| Наличие: | В наличии |
-
700грн.
Учебное пособие "Практикум по дерматологии и венерологии" (3-е издание) под авторством В. И. Степаненко, А. И. Чоботаря, С. А. Бондаря и других является актуальным и практически ориентированным ресурсом для студентов медицинских учреждений высшего образования. Пособие включает основные аспекты диагностики, лечения и профилактики заболеваний кожи и венерических инфекций.
Основное внимание уделяется клиническим аспектам дерматологии и венерологии, что делает это руководство незаменимым инструментом в подготовке медицинских специалистов. Студенты могут не только ознакомиться с теоретическими основами, но и получить практические навыки диагностики и терапии на основе реальных клинических случаев, что делает материал более понятным и доступным для практического использования.
Руководство содержит подробное описание основных дерматологических заболеваний, включая их этиологию, патогенез, клинические проявления и методы лечения. В разделах, посвященных венерологии, рассматриваются наиболее распространенные заболевания, пути их передачи и методы профилактики и лечения.
Книга также содержит многочисленные задачи для самостоятельной работы, ситуационные задачи и контрольные вопросы, способствующие закреплению полученных знаний и развитию клинического мышления. Издание адаптировано к учебным программам высших медицинских учебных заведений Украины и отвечает требованиям подготовки студентов по специальности "Дерматология и венерология".
Этот практикум станет полезен студентам, интернам, врачам-дерматологам и венерологам, а также всем, кто интересуется вопросами кожных и венерических заболеваний.
| Характеристики книги | |
| ISBN | 978-617-505-855-8 (9786175058558) |
| Автор | В.И. Степаненко, А.И. Чеботарь, С.А. Бондарь и др. |
| Вес | 500 г |
| Год издания | 2120 |
| Издательство | Всеукраинское специализированное издательство «Медицина» |
| Иллюстрации | черно-белые |
| Количество страниц | 360 |
| Обложка | твердая |
| Формат | 60х90/16 |
| Язык издания | украинский |